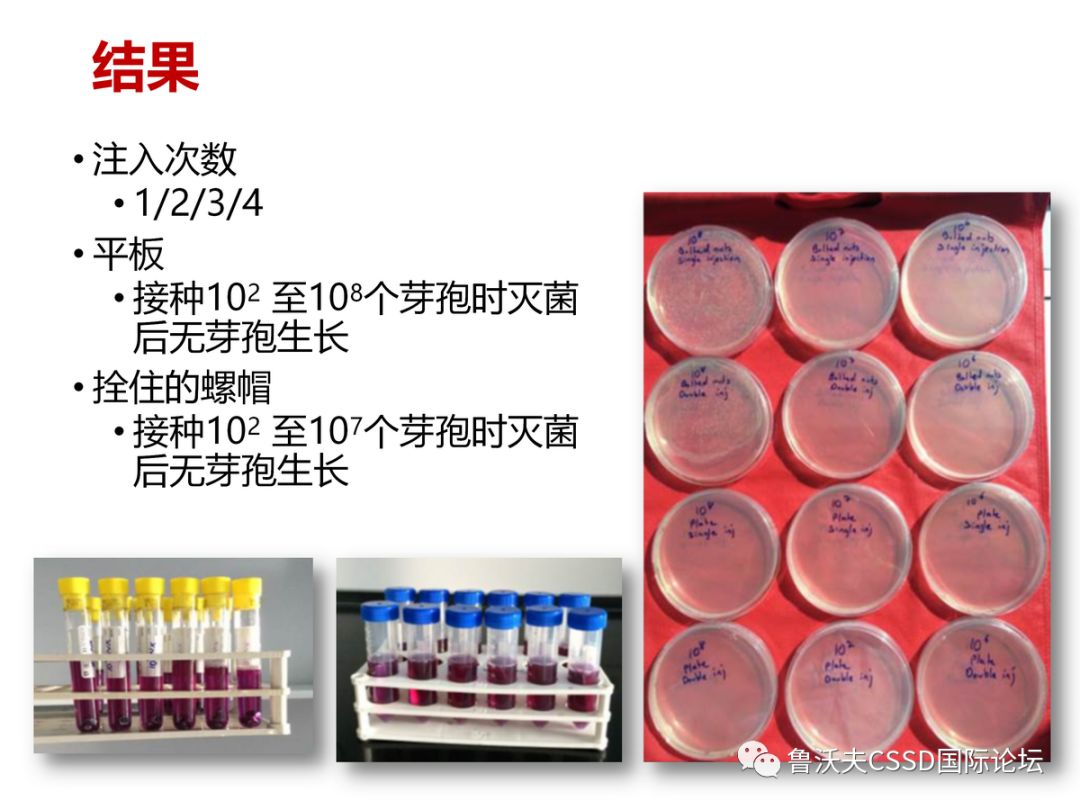
图片

明誉医疗科技有限公司
PPT低温灭菌方式选择发表时间:2025-02-24 11:19
                                                  
—————————————————— 为人类感控事业而奋斗——明誉医疗 |
PPT低温灭菌方式选择发表时间:2025-02-24 11:19
—————————————————— 为人类感控事业而奋斗——明誉医疗 |